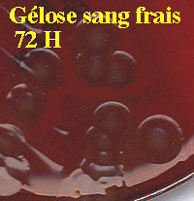

| Ce genre bactérien se caractérise bien sur le plan morphologique: bacilles à Gram-négatif incurvés et très mobiles (colonies plates). Leurs caractères nutritifs leur permet de supporter de fortes concentrations de sel et donc de survivre dans divers environnements hydriques (eaux de mer, eaux saumätres). La contamination est donc le plus souvent alimentaire ou hydrique. Diverses espèces sont décrites chez l'homme dont V. cholerae. D'autres espèces, halophiles (exigence d'ions Na+) sont isolées chez l'animal, poissons ou crustacés par exemple, telles V. parahaemolyticus, responsabae de toxi-infections alimentaires comme au Japon. D'autres espèces telles V. alginolyticus ou encore V. vulnificus ont été observées dans des suppurations. |
VIBRIO CHOLERAE
 |
Le choléra est une maladie diarrhéique très contagieuse, due à un bacille à Gram négatif, Vibrio cholerae. Cette bactérie pathogène a un tropisme exclusivement digestif et vit à l'état saprophyte dans l'eau des estuaires et parasite du zooplancton. Les souches bactériennes responsables du choléra sont transmises par voie orale à partir d’eau ou d’aliments contaminés et appartiennent aux sérovars O1 et O139. Le traitement du choléra est basé sur la réhydratation rapide des patients. |
A - LE CHOLÉRA
Le choléra est une maladie strictement humaine entrainant une diarrhée avec une déshydratation aiguë. Après une courte incubation (quelques heures à 5 jours), la maladie débute par une diarrhée fécaloïde, puis aqueuse sans fièvre, associée à des douleurs violentes épigastriqures et abdominales et des vomissements en fusée.
La diarrhée devient incoercible, avec des grains riziforme, déshydratation aiguë et hypothermie et collapsus cardio-vasculaire.


Cependant, l’infection par V. cholerae est souvent asymptomatique (90% des cas), avec élimination des bactéries dans les selles pendant plusieurs jours. Le spectre de la maladie va de la diarrhée banale (10% des sujets infectés) et au choléra sévère (1% des infectés).
B - ÉPIDÉMIOLOGIE DU CHOLÉRA
Les sept pandémies de choléra
Depuis le début du XIXème siècle, sept pandémies se sont succédées jusqu'à nos jours. A partir de 1817, les six premières pandémies parties du delta du Gange et du Bangladesh, sont dues à des souches de V. cholerae O1 biovar Cholerae (dit classique). En 1961, une souche O1 d’un nouveau biovar Eltor, provenant des îles Célèbes, a émergé et provoqué la 7ème pandémie, qui atteignit en 1961 l'Afrique et l'Amérique latine en 1991. Le choléra s'est installé à l'état endémique en Afrique, Asie et Amérique latine.


En 1992 , une nouvelle souche épidémique inconnue jusque-là fut responsable d’une grave épidémie de choléra en Inde et au Bangladesh. Cette souche était apparentée au biovar Eltor et présentait un nouveau sérovar dit O139. On peut redouter que cette nouvelle souche, implantée à l'état endémique en Inde et au Bangladesh soit à l'origine d'une 8ème pandémie.


C - HABITAT ET TRANSMISSION DU CHOLÉRA
V. cholerae est une bactérie saprophyte retrouvée dans l’environnement , particulièrement dans les eaux saumâtres des estuaires, les lits des fleuves et au contact du zooplancton (copépodes), des algues marines et des plantes aquatiques dans la plupart des zones côtières des régions tempérées ou tropicales du monde.. La bactérie peut contaminer les fruits de mer et l’ intestin des poissons. Elle survit pendant 50 jours dans l'eau de mer à 5-10°C, 10-12 jours à 30-32°C, expliquant son existence saprophytique et sa persistence limitée aux zones intertropicales. Les souches de sérovar O1 (LPS) semble particulièrement adapté à l’intestin humain. La virulence et le caractère épidémique des souches pathogènes proviendraient de l'acquisition séquentielle par une souche O1 de gènes de virulence portés par des phages, des transposons ou des plasmides, et codant des toxines et des pili. L'histoire du choléra illustre la dynamique d'adaptation d'un agent pathogène à son hôte en fonction de l'environnement, de la résistance naturelle et du comportement des populations qu'il infecte.
V. cholerae est transmis par voie orale par les aliments et l'eau de boisson contaminés. Au cours du choléra, V. cholerae est éliminé pendant 5-10 jours en très fortes quantités (109 bactéries / ml) dans les selles aqueuses des patients (parfois 10-20 l/ jour). Les porteurs sains très nombreux au cours des épidémies sont un important vecteur de propagation du choléra. La dose infectante est élevée chez les personnes sans facteur de risque, notamment à cause de l’acidité gastrique (>108 bactéries). En présence de bicarbonate de soude ou absorbées avec des aliments, des doses de 103-104 suffisent à déclencher la diarrhée.
Le risque de contamination en zone d’endémie vient de l’eau stagnante massivement polluée (égouts, fèces) et de la contamination des mains qui contribuent à la contamination de la nourriture. Le choléra est une maladie des mains sales. La cuisson de l’eau et des aliments est une protection simple et efficace de la propagation de la maladie.
D - PHYSIOPATHOLOGIE DU CHOLÉRA
La diarrhée du choléra
Les vibrions sont absorbés par voie orale avec l’eau de boisson ou les aliments après contact direct avec des patients ou des porteurs sains. L’acidité gastrique protège partiellement de la contamination. Les bactéries se multiplient alors dans la lumière de l'intestin grêle et traversent la couche de mucus tapissant la muqueuse intestinale.


Les bactéries adhèrent intimement à la bordure en brosse des entérocytes par des pili de type IV constitués de la protéine TCP(gène tcpA) qui interagissent à des récepteurs inconnus. Les pili sont codés par une quinzaine de gènes formant un îlot de pathogénicité porté par le phage VPIØ.
Le syndrome diarrhéique est dû à la sécrétion in situ d'une exotoxine protéique qui entraîne une fuite d'eau et d'électrolytes. Cette toxine est une protéine thermolabile composée d’ une sous-unité H (ou A) de 28 kDa et de 5 sous-unités L (ou B) de 8 kDa. L'exotoxine se fixe par ses sous-unités L au ganglioside GM1, récepteur glycolipidique de la membrane des entérocytes. La sous-unité H est une pro-enzyme avec activité ADP-ribosylase révélée par protéolyse. Cette ADP-ribosylase libérée dans le cytoplasme active l'adénylcyclase des entérocytes en bloquant la sous-unité a de la protéine Gs qui normalement inhibe cette enzyme. Ceci induit une augmentation de l'AMPc intracellulaire, et provoque l'excrétion anormale d'ions sodium et la fuite hydrique.


| Les gènes ctxA et ctxB de la toxine cholérique sont localisés le phage filamenteux CTXØ formant un îlot de pathogénicité de 4,5 kb. Fait intéressant, les pili eux-mêmes sont les récepteurs du phage CTX Ø, suggèrant que les souches virulentes piliées et toxinogènes proviennent de l’acquisition successive du phage codant pour les pili, puis de celui codant pour la toxine cholérique. |
 |
Le LPS jouerait aussi un rôle dans la colonisation de l'épithélium intestinal et dans la pathogénie de la maladie, peut-être par production de cytokines par l'épithélium. Les gènes codant pour le LPS forment un autre îlot de pathogénicité (22 kb pour le LPS O1, et 37 kb pour le LPS O139). Le LPS est un antigène protecteur majeur induisant l'apparition d'anticorps vibriocides protecteurs.
Les gènes de virulence de V. cholerae (plus de 17 gènes, dont ctxA et ctxB et ceux des pili) sont contrôlés par le gène toxR codant pour un activateur transcriptionnel. ToxR est induit par des stimuli environnementaux (température, pH, osmolarité).
Immunité
L’immunité contre V. cholerae est essentiellement humorale et de courte durée (2 à 3 ans). En zone d'endémie, les enfants paient un lourd tribu à la maladie, alors que les adultes sont relativement épargnés du fait de contaminations itératives qui leur confèrent une immunité parfois abrogée par la malnutrition. L’immunité contre V. cholerae est liée à la capacité de coloniser les plaques de Peyer de la muqueuse intestinale. Les bactéries ingérées par les cellules M des plaques de Peyer sont transportées aux macrophages qui les détruisent et les présentent aux lymphocytes T et B. La toxine fixée est aussi transférée par transcytose aux lymphocytes de la lamina propria. Les lymphocytes B des plaques de Peyer et de la lamina propria sécrètent dans la lumière intestinale des immunoglobulines, notamment de type IgA et IgG, qui sont des anticorps opsonisants et vibriocides anti-pili et anti-LPS et des anticorps neutralisant la toxine cholérique. On peut détecter chez les sujets exposés à V. cholerae la présence d’anticorps sériques agglutinants et bactéricides, avec un pic à la 2ème semaine, qui vont ensuite disparaître en 4 semaines.
E - DIAGNOSTIC DU CHOLÉRA
Examen microscopique des selles
Chez les patients cholériques, on le met en mise exclusivement dans les selles et parfois sur la peau. Au cours du choléra dans les formes sévères, les vibrions sont visibles en très grande abondance et très mobiles à l’état frais dans les selles aqueuses. V. cholerae est un un bacille à Gram négatif en virgule (comma), très mobile avec un cil polaire (monotriche).


Isolement et identification en culture
| Chez les patients cholériques, V. cholerae est facilement isolé en culture presque pure sur géloses ordinaires ou alcalines (pH 9,6) ou sur certains milieux type TCBS (thiosulfate, citrate, sels biliaires, saccharose), incubés à 37°C. Les colonies apparaissent en 8h à 10h, de 2-3 mm, transparentes (‘’comme du verre’’). Chez les sujets porteurs sains ou avec simple diarrhée, il convient d’utiliser des milieux d’enrichissement type bouillon alcaline hypersalée ou eau peptonée pour isoler les germes souvent en faibles quantités |
 |

V. cholerae est une bactérie oxydase+, aéro-anaérobie, capable de respirer et de fermenter les sucres. Le diagnostic est d'abord biochimique. Les bactéries fermentent plusieurs sucres sans production de gaz : incluant le glucose et le D-saccharose. En eau peptonée, on peut réaliser la réaction dite du choléra-roth, mettant en évidence la production d’ indole-nitrite avec l’acide sulfurique. Les conditions de croissance de V. cholerae sont: (1) une température optimale entre 30-37°C; (2) une tolérance au NaCl (halotolérance: 1-3%) , inhibition à 7% de NaCl; (3) un pH de croissance de 7 à 10, la multiplication étant inhibée à pH acide (pH < 6 ). V. cholerae sécrète de nombreuses enzymes (lécithinase, lipase, amylase) et produit certains enzymes métaboliques (ornithine décarboxylase ODC+).


Les biovars: On distingue 2 biovars principaux : le biovar Cholerae (ou classique) correspondant aux souches de la 6ème pandémie et le biovar Eltor retrouvé chez les souches de la 7ème pandémie.
Les sérovars: V. cholerae présente une grande diversité clonale (>73 électrotypes) et des sérovars définis par la structure antigènique du lipopolysaccharide (LPS) (>170 sérovars). Seuls, un très petit nombre de sérovars sont retrouvés dans les souches à potentiel épidémique : les souches épidémiques appartiennent uniquement aux sérovars O1 et O139. Les souches dites non-O1-non-O139 proviennent de l’environnement et sont rarement à l’origine de cas sporadiques de diarrhée banale sans potentiel épidémique dans le monde entier. A part, des souches dites O1 endémiques, responsables de diarrhées sans gravité aux USA et en Australie, dues à des contaminations de fruits de mer.
Sérovars et biovars de V. cholerae en fonction de leur potentiel épidémique.
Recherche par agglutination rapide sur lame

F - TRAITEMENT DU CHOLÉRA
Le traitement du choléra est basé sur la réhydratation d'urgence, par voie veineuse, pour compenser les pertes hydro-électrolytiques massives observées chez certains patients. Des solutés hydro-électrolytiques standardisés ont été proposés par l'OMS, par exemple la solution contenant : Na+ 135 mEq/L, K+ 15 mEq/L, HCO3- 40 mEq/L, Cl- 100 mEq/L (osmolarité totale 290 mEq/l). Cette réhydratation d'urgence entraîne une amélioration clinique rapide. Ce traitement seul suffit à guérir du choléra car les défenses immunitaires sont capables d'éliminer complètement le germe en quelques jours. Cependant, il est évident que la destruction des vibrions dans l'intestin hâtera la guérison, le traitement d'appoint est basé sur l'administration pendant 4 jours, d'une dose de tétracycline de 2 g chez l'adulte et 25-50 mg/kg/j chez l'enfant, ou de triméthoprime-sulfaméthoxazole (480 mg, 2 400 mg/j chez l’adulte; 6 mg/30 mg/kg/j chez l'enfant) en 4 prises orales. Ce traitement réduit le risque de dissémination du germe qui disparaît des selles en quelques heures. Cependant, il existe des souches de V. cholerae résistantes à la tétracycline, et parfois poly-résistantes à divers antibiotiques par acquisition de plasmides.
E- PROPHYLAXIE DU CHOLÉRA
La prophylaxie du choléra est basée sur le contrôle de la dissémination du germe et sur la diminution de l'état de réceptivité des sujets sains par la vaccination. Le contrôle de la dissémination se fait par des mesures d'hygiène simple: désinfection des mains du personnel soignant, désinfection par des antiseptiques des selles, des vomissements et des objets contaminés. Des mesures collectives sont aussi indispensables et efficaces: amélioration des conditions sanitaires, de la qualité des eaux de boisson et des installations sanitaires, des habitudes d'hygiène individuelles. Les différents vaccins testés sont administrés par sous-cutanée, intradermique ou buccale. Longtemps, le seul vaccin disponible était constitué de bactéries entières (V cholerae O1) tués par le phénol et injecté par voie parentérale (2 doses à 15 jours d’intervalle). Ce vaccin ne confère qu’une protection contre le choléra de 50% pendant seulement 6 mois. Deux vaccins oraux ont été proposés. Le vaccin tué WC/rBS constitué de V cholerae O1 tués avec sous-unité B recombinante de la toxine cholerique (WC/rBS) conférant une protection de 85-90% pendant 6 mois et une protection de 50-60% pendant au moins 3 ans. Le vaccin vivant atténué CVD 103-HgR est constitué d’une souche vivante atténuée de V cholerae O1 génétiquement manipulée qui donnerait un taux de protection de >80% durant au moins 6 mois contre V cholerae O1. Ce vaccin est bien toléré, même chez l’immunodéprimé et les femmes enceintes Cependant, il faut savoir que les vaccins disponibles ne protègent pas contre V cholerae O139 et n'empêchent pas le portage des bactéries, et donc la dissémination de la maladie sujets réceptifs. Les campagnes de vaccination permettent néanmoins d'améliorer l'état sanitaire de la population et de contrôler la propagation de la maladie.
Ce cours a été préparé par le Professeur P. Berche (Faculté de Médecine Necker-Enfants Malades, PARIS V)
Pour en savoir plus :

|
|
|
|
|
